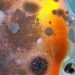
Decoding Indoor Mold Varieties: Health Risks and Remediation

Mold is a common problem in many homes, and its presence can lead to various health issues and structural damage. Homeowners often consider DIY mold remediation as an affordable and convenient method to address this issue. However, before embarking on this journey, it’s vital to understand the risks and safety precautions involved in DIY mold remediation to ensure the job is done effectively and, more importantly, safely.

Understanding mold and its risks is crucial before beginning any remediation project. While some types of mold are relatively harmless, others can produce allergens and irritants that cause health problems, especially for individuals with allergies or compromised immune systems. In addition, improper handling of mold can lead to its spreading, causing more damage and health risks.
When tackling a DIY mold remediation project, it’s essential to take safety precautions and follow a step-by-step guide to remove mold effectively. However, recognizing when DIY mold remediation is insufficient is crucial. In some cases, it might be safer and more effective to seek professional mold remediation services, especially if the mold problem is extensive or hazardous.
Key Takeaways
- DIY mold remediation can be effective but requires understanding the risks and taking necessary safety precautions.
- Following a step-by-step guide is crucial to ensure safe and effective mold removal.
- Professional mold remediation services should be considered when DIY efforts are insufficient or the mold problem is hazardous.
Understanding Mold and Its Risks

Mold is a type of fungus that grows in moist environments and can produce tiny spores that become airborne and cause various health issues when inhaled. In this section, we will discuss the common types of mold and the health implications associated with mold exposure.
Types of Mold
There are many different types of mold, but three main types often cause problems in homes and other buildings:
- Aspergillus: This mold is commonly found on food and in air conditioning systems. It can cause allergic reactions and respiratory problems.
- Cladosporium: Typically found on surfaces such as wood and textiles, Cladosporium can also cause allergies and respiratory issues.
- Stachybotrys chartarum: Also known as “black mold,” this type of mold produces toxic mycotoxins that can trigger severe health issues, including memory loss and long-term respiratory problems.
It is crucial to identify the type of mold present in a building to understand the potential risks and the appropriate mold remediation methods.
Health Implications
Exposure to mold spores can lead to several health issues, particularly for individuals with preexisting respiratory conditions or compromised immune systems. Some common health implications related to mold exposure include:
- Allergic reactions: Symptoms may include sneezing, runny or stuffy nose, itchy or watery eyes, and skin rashes.
- Respiratory issues: Mold spores can irritate the lungs, causing coughing, wheezing, and difficulty breathing, especially for individuals with asthma or other respiratory conditions.
- Mycotoxin exposure: Certain molds, such as black mold, produce toxic substances called mycotoxins. Prolonged exposure to mycotoxins can lead to more severe health problems like memory loss, cognitive impairment, and even organ damage.
Knowing the types of mold present and understanding the associated health risks is an essential first step in determining whether DIY mold remediation is a safe option or if professional help is necessary.
DIY Mold Remediation Overview

When to Consider DIY
DIY mold remediation can be a practical solution for minor mold problems. Homeowners may opt for this approach when the affected area is small and easily accessible. It’s essential to address mold growth promptly, as it may cause various health issues and structural damage to the property. DIY mold removal can be a cost-effective and convenient option compared to hiring professional services. However, it’s crucial to have some basic knowledge and understanding of the mold removal process to ensure a successful DIY project.
Potential Benefits and Drawbacks
Benefits:
- Cost-effective solution: DIY mold remediation typically requires a lower financial investment compared to hiring professional services.
- Convenience: With DIY mold removal, the homeowner can tackle the issue at their own pace without the need to wait for scheduled appointments or work around professionals’ availability.
Drawbacks:
- Limited expertise: With DIY mold remediation, the homeowner may not have the same level of knowledge and experience as professional mold remediators. This could result in an increased risk of incomplete remediation or further damage to the property.
- Incomplete remediation: DIY mold removal may not successfully address the root cause of the problem, leaving the potential for mold to reappear. Moreover, if the mold infestation is extensive, a DIY approach may not be sufficient.
When considering a DIY approach to mold removal, it’s crucial to weigh the potential benefits and drawbacks and thoroughly assess the extent of the mold issue. DIY mold remediation can be a cost-effective and convenient solution for minor mold problems, but tackling more extensive infestations might require professional expertise. Taking necessary precautions and using proper techniques, the homeowner can effectively address mold growth while minimizing the potential risks associated with DIY mold removal.
Safety Precautions for DIY Mold Remediation

Protective Gear
When undertaking DIY mold remediation, wearing appropriate protective gear is crucial to ensure your safety. At a minimum, you should use an N-95 respirator, gloves, and safety goggles to protect your eyes, nose, and skin. A respirator mask can help filter spores and particles to prevent inhalation, while gloves and goggles ensure no direct contact with mold or chemicals.
Essential protective gear:
- N-95 respirator
- Gloves (preferably rubber or nitrile)
- Safety goggles
Proper Area Preparation
Before beginning mold remediation, it is important to take necessary safety precautions and prepare the affected area properly. Start by sealing off the room to prevent mold spores from spreading to other parts of the house. You can use plastic sheeting and painter’s tape to cover doorways, windows, and vents. Then, place a window fan facing outward to help with ventilation and direct airflow outside during cleanup.
Area preparation steps:
- Seal off the room with plastic sheeting and painter’s tape.
- Cover doorways, windows, and vents to prevent spore transmission.
- Use a window fan to improve ventilation.
Following these safety precautions and wearing appropriate protective gear is essential for safe DIY mold remediation. Proper area preparation helps contain the mold and minimize the risk of spreading throughout your home.
Step-by-Step Guide for Removing Mold

Identifying Mold Infestation
The first step in DIY mold remediation is to identify the presence of mold in your home. Mold can appear as discolored spots or patches on walls, ceilings, and other surfaces. It can also cause a musty odor in the affected area. While some types of mold are visible, others can hide behind walls or beneath flooring, making them difficult to detect.
Necessary Tools and Materials
Before starting the mold removal process, gather the necessary tools and materials:
- Protective gear (gloves, goggles, respiratory mask)
- Cleaning agents (bleach, vinegar, hydrogen peroxide, borax, or detergent)
- Spray bottle
- Soft-bristle brush or sponge
- HEPA vacuum
- Plastic sheeting
- Painter’s tape
Remember, it’s important to choose the right cleaning agent for your specific situation. For example, bleach works well on non-porous surfaces like tile, but it may not be effective on porous materials like wood.
Mold Removal Process
- Contain the affected area: Cover entryways, vents, and furniture with plastic sheeting and use painter’s tape to seal the edges. This will prevent mold spores from spreading to other parts of your home.
- Ventilate the area: Open windows and doors to ensure proper ventilation, helping to reduce humidity and improve air circulation.
- Apply the cleaning agent: Choose your preferred cleaning agent (bleach, vinegar, hydrogen peroxide, borax, or detergent) and mix it with water according to the manufacturer’s instructions. Pour the solution into a spray bottle and apply it directly to the moldy surfaces.
- Scrub the mold: Using a soft-bristle brush or sponge, gently scrub the affected surfaces to remove the mold. Be careful not to damage the material beneath the mold.
- Rinse and dry the area: After removing the mold, rinse the area thoroughly with clean water to remove any remaining cleaning residue. Allow the surfaces to dry completely.
- Vacuum with a HEPA vacuum: Use a HEPA vacuum to clean up any remaining mold spores and debris. This type of vacuum is designed to trap even the smallest particles, ensuring a thorough cleaning.
- Dispose of materials safely: After the mold removal process is complete, dispose of any moldy materials and cleaning supplies in sealed plastic bags.
Following this process can help in safely removing mold growth from your home. However, for severe mold infestations, it is recommended to consult a professional mold remediation expert to avoid any potential risks to your health and property.
Professional Mold Remediation Services
When to Seek Professional Help
DIY mold remediation can be convenient, but it has its limitations in terms of expertise and safety. It is important to recognize when professional mold remediation services are needed. Seek professional help if you:
- Encounter mold covering an area larger than 10 square feet
- Suspect mold inside walls, ceilings, or HVAC systems
- Notice recurring mold, even after trying DIY removal
- Have health problems aggravated by mold exposure
What to Expect from Experts
Expertise & Certification: Professional mold remediation services are certified and trained in handling and eliminating mold problems. Certifications, such as the IICRC, ensure that professionals adhere to strict industry guidelines and maintain up-to-date knowledge of mold removal techniques.
Assessment & Planning: The experts will assess the mold situation and create a customized remediation plan. This plan will cover the extent of the infestation and the methods to effectively eliminate the mold, while also addressing the underlying moisture issue.
Safety & Equipment: Professional services prioritize safety and use appropriate personal protective equipment (PPE). They also employ advanced tools and techniques that are necessary to minimize the potential risks associated with mold removal.
Mold Removal & Prevention: Professionals not only remove the visible mold but also address the root cause of the problem. By fixing water leaks or improving ventilation, they help to prevent mold from recurring in the future.
Hiring a professional mold remediation service can provide peace of mind and ensure the thorough and safe removal of mold from your property.
Preventing Future Mold Growth
One critical aspect of mold remediation is taking preventative measures against future mold growth. This section will provide tips and insights on how to maintain a mold-free environment in your home after completing the mold removal process.
Maintaining Dry Conditions
Keeping your home dry is essential in mold prevention. Mold thrives in humid environments, so it is crucial to maintain indoor humidity levels within the recommended 30-50% range1. Using a dehumidifier can help maintain optimal humidity levels, especially in damp areas such as basements or bathrooms.
Ensure proper ventilation throughout your home by making use of exhaust fans in moisture-prone rooms like kitchens, bathrooms, and laundry rooms. In addition, address any potential sources of water intrusion, such as leaks in roofs, walls, and plumbing2.
Regular Cleaning and Inspection
Implementing a routine cleaning and inspection schedule can prevent future mold growth. Focus on areas where mold is more likely to form, such as bathrooms, kitchens, and basements. CDC’s recommendations include using mold inhibitors in paints before applying them to walls and cleaning with mold-killing products in moisture-prone areas.
Here are some essential steps in the cleaning and inspection process:
- Inspect: Check for any water leaks, dampness, and condensation in your home.
- Clean: Wipe down surfaces at risk of mold, using mild detergents or mold-killing products.
- Ventilate: Open windows and use exhaust fans to remove moisture and promote air circulation.
- Maintain: Regularly clean and maintain your home’s HVAC system3 to ensure proper air circulation and moisture control.
By following these preventative measures and maintaining a dry, clean environment, you can significantly reduce the risk of future mold growth in your home.
Footnotes
The Role of Humidity and Ventilation
HVAC Systems and Mold
Humidity plays a significant role in mold formation, with ideal indoor humidity levels ranging between 30-50 percent. When humidity rises above 50 percent, especially during warmer months, it creates a moist environment where mold thrives. HVAC systems are essential in maintaining proper humidity levels, thus preventing mold growth.
A well-maintained HVAC system provides sufficient ventilation, controlling moisture sources and regulating indoor air quality. When systems are poorly maintained or inadequate for the living space, moisture accumulates, leading to potential mold problems. Some common signs of HVAC-related mold include musty odors and unsightly discoloration around vents.
To prevent mold growth, it’s important to:
- Regularly clean and replace air filters.
- Inspect and maintain ducts to remove debris, moisture, or microbial growth.
- Ensure proper condensate drainage to avoid water leaks.
Using Dehumidifiers to Control Moisture
In addition to HVAC systems, dehumidifiers can be useful in controlling indoor humidity and preventing mold growth. Dehumidifiers work by extracting excess moisture from the air, reducing the risk of mold formation on surfaces.
Consider using dehumidifiers in areas prone to high humidity, such as basements or bathrooms, or in rooms with poor ventilation. When selecting a dehumidifier, make sure to choose one with appropriate capacity based on room size and moisture levels.
Maintaining proper humidity and ventilation in your home not only reduces the risk of mold growth but also ensures a healthier and more comfortable living environment. Regularly monitoring and addressing humidity problems is an essential aspect of mold prevention and remediation.
Recognizing When DIY is Insufficient
Limitations of DIY Methods
When attempting to remove mold yourself, it’s important to understand that DIY methods have certain limitations. The primary concern is the potential dangers associated with mold exposure. Mold can be dangerous, especially if exposure leads to severe health issues such as respiratory problems, eye irritation and allergic reactions.
Additionally, while DIY mold remediation might be suitable for minor mold problems, it might not be best for serious infestations that require proper expertise and use of professional tools. Common mildew cleaning techniques like scrubbing and using over-the-counter products might not be as effective as professional services.
Signs You Need Professional Assessment
If you suspect that you have a larger mold issue, there are several signs that it’s time to call in a professional assessment. These signs include:
-
Extensive Mold Growth: If the mold growth exceeds a small area, such as more than 10 square feet, you may need professional assistance.
-
Persistent Mold Issues: If you have tried various DIY methods, and the mold keeps returning, it’s indicative of a deeper issue that requires professional help.
-
Mold-Infested Materials: Certain mold-prone materials, like drywall or insulation, may be beyond saving and need proper disposal by a certified expert.
-
Mycotoxins Presence: If you suspect the presence of dangerous mycotoxins (toxic mold), do not try to handle it yourself. Leave it to professionals who have the certification and necessary tools and materials for safe removal.
-
Health Concerns: If you or your family members are experiencing health symptoms such as respiratory issues or continuous allergic reactions, seeking professional help is crucial.
Moreover, a professional mold remediation company will employ advanced equipment such as air scrubbers, fans and dehumidifiers that ensure effective mold removal and prevent future recurrence. In conclusion, recognizing the limitations of DIY methods and knowing the signs when professional help is required can protect your health and your property from the hazards of mold infestation.
Frequently Asked Questions
What are the recommended steps for bathroom mold removal?
To remove mold from your bathroom, start by using a soft brush and a bleach solution to scrub the moldy surfaces. After scrubbing, allow the bleach solution to penetrate the surfaces and dry. Do not rinse off the bleach solution. If you’re dealing with mold on concrete, scrub with TSP or automatic dishwasher detergent source.
Can DIY mold removal be hazardous to your health?
DIY mold removal can be hazardous if proper safety precautions are not taken. Exposure to mold can lead to allergies and health issues, especially for individuals with a weakened immune system or underlying lung disease source.
What natural methods are effective for purifying air of mold spores?
Some natural methods for purifying air of mold spores include using air purifiers with HEPA filters, increasing ventilation in your home, and using certain essential oils, such as tea tree oil and eucalyptus oil.
Under what circumstances is professional mold remediation necessary?
Professional mold remediation may be necessary if the mold infestation is extensive, has infiltrated hard-to-reach areas, or if you’re dealing with toxic mold source. It’s also important to consider your own expertise and safety risks when deciding between DIY and professional remediation.
What does the Environmental Protection Agency suggest for mold remediation?
The Environmental Protection Agency (EPA) suggests using a mix of soap or detergent, water, and a soft brush to remove mold from non-porous surfaces. They discourage using bleach or other biocides unless necessary, as these can be harmful to both humans and the environment source.
How should mold be safely removed from interior walls?
To safely remove mold from interior walls, start by addressing the source of the moisture that is causing the mold. Then, use a soft brush and a mixture of soap, water, and bleach to remove the mold. Apply the solution to the moldy area, let it sit for a few minutes, and then scrub with the brush. Allow the surface to dry completely before repainting, if necessary source.